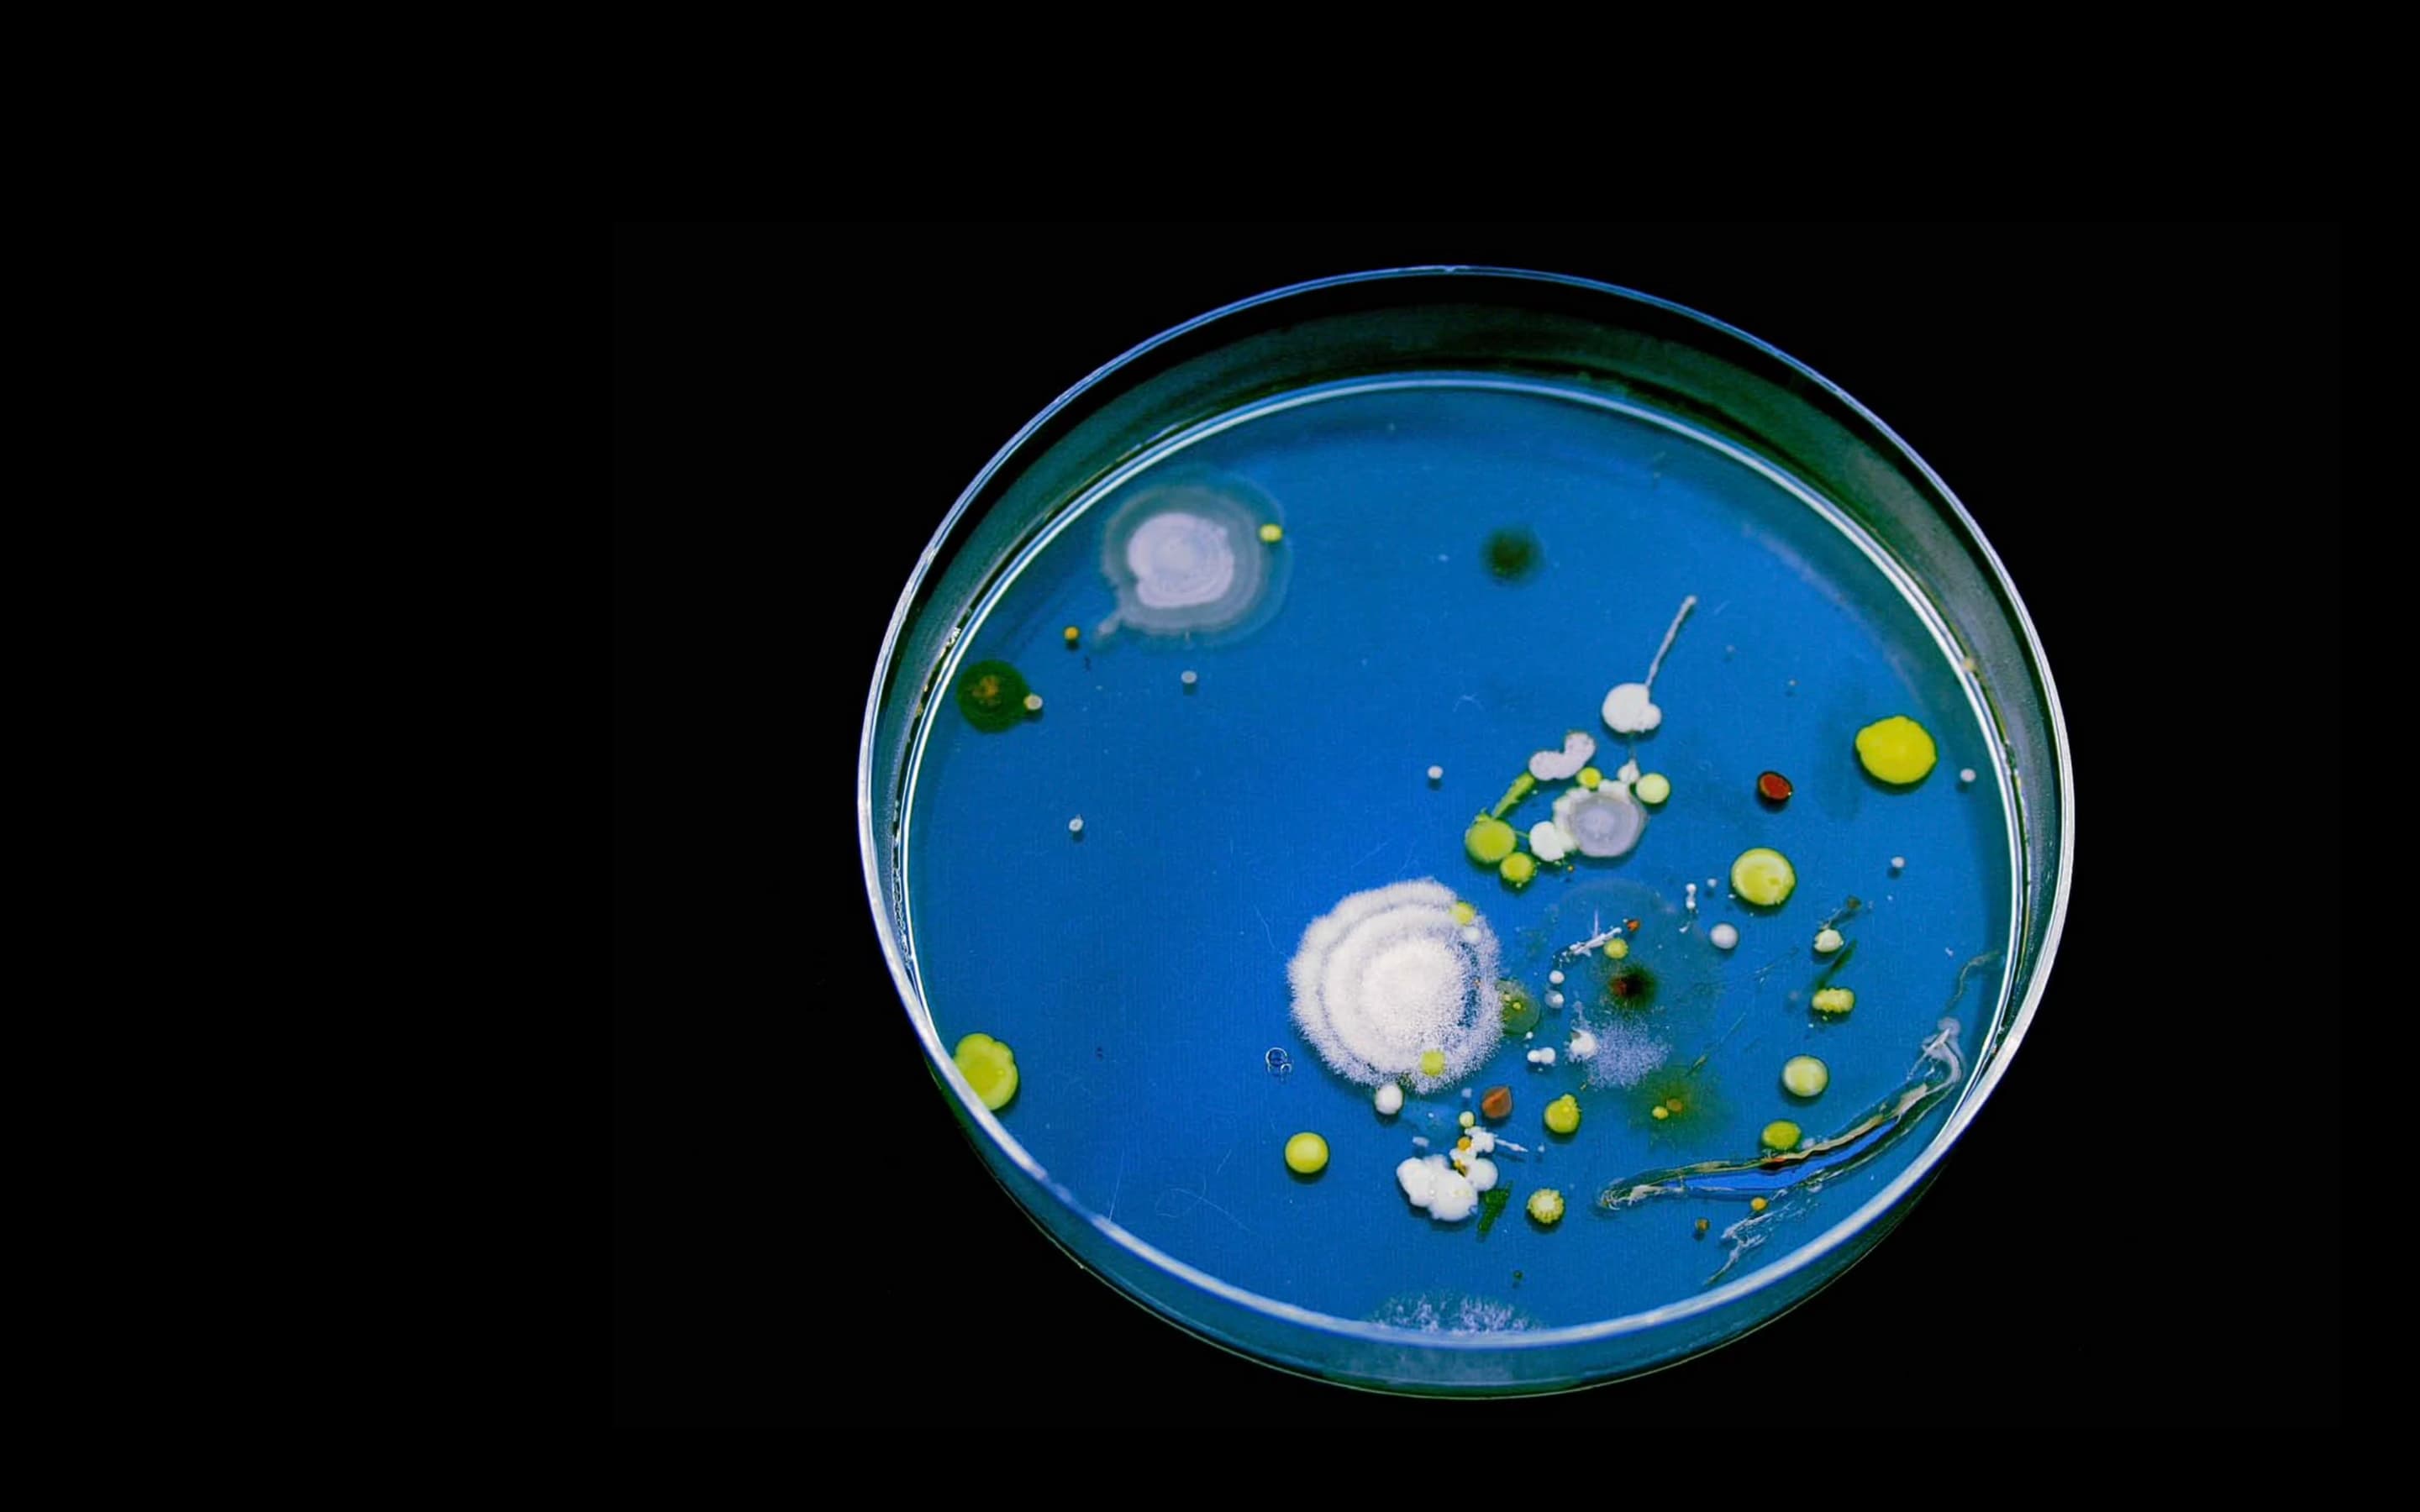

I’m Hilal Koyuncu.
I’ve been a designer for 15 years, leading teams and building small to large scale products enjoyed by billions.
I help companies design their MVPs, build their first design teams and uplevel their products.
I’m Hilal Koyuncu. I’ve been a designer for 15 years, leading teams and building small to large scale products enjoyed by billions.
I help companies design their MVPs, build their first design teams and uplevel their products.
I’m Hilal Koyuncu.
I’ve been a designer for 15 years, leading teams and building small to large scale products enjoyed by billions.
I help companies design their MVPs, build their first design teams and uplevel their products.
Scroll down to see selected work